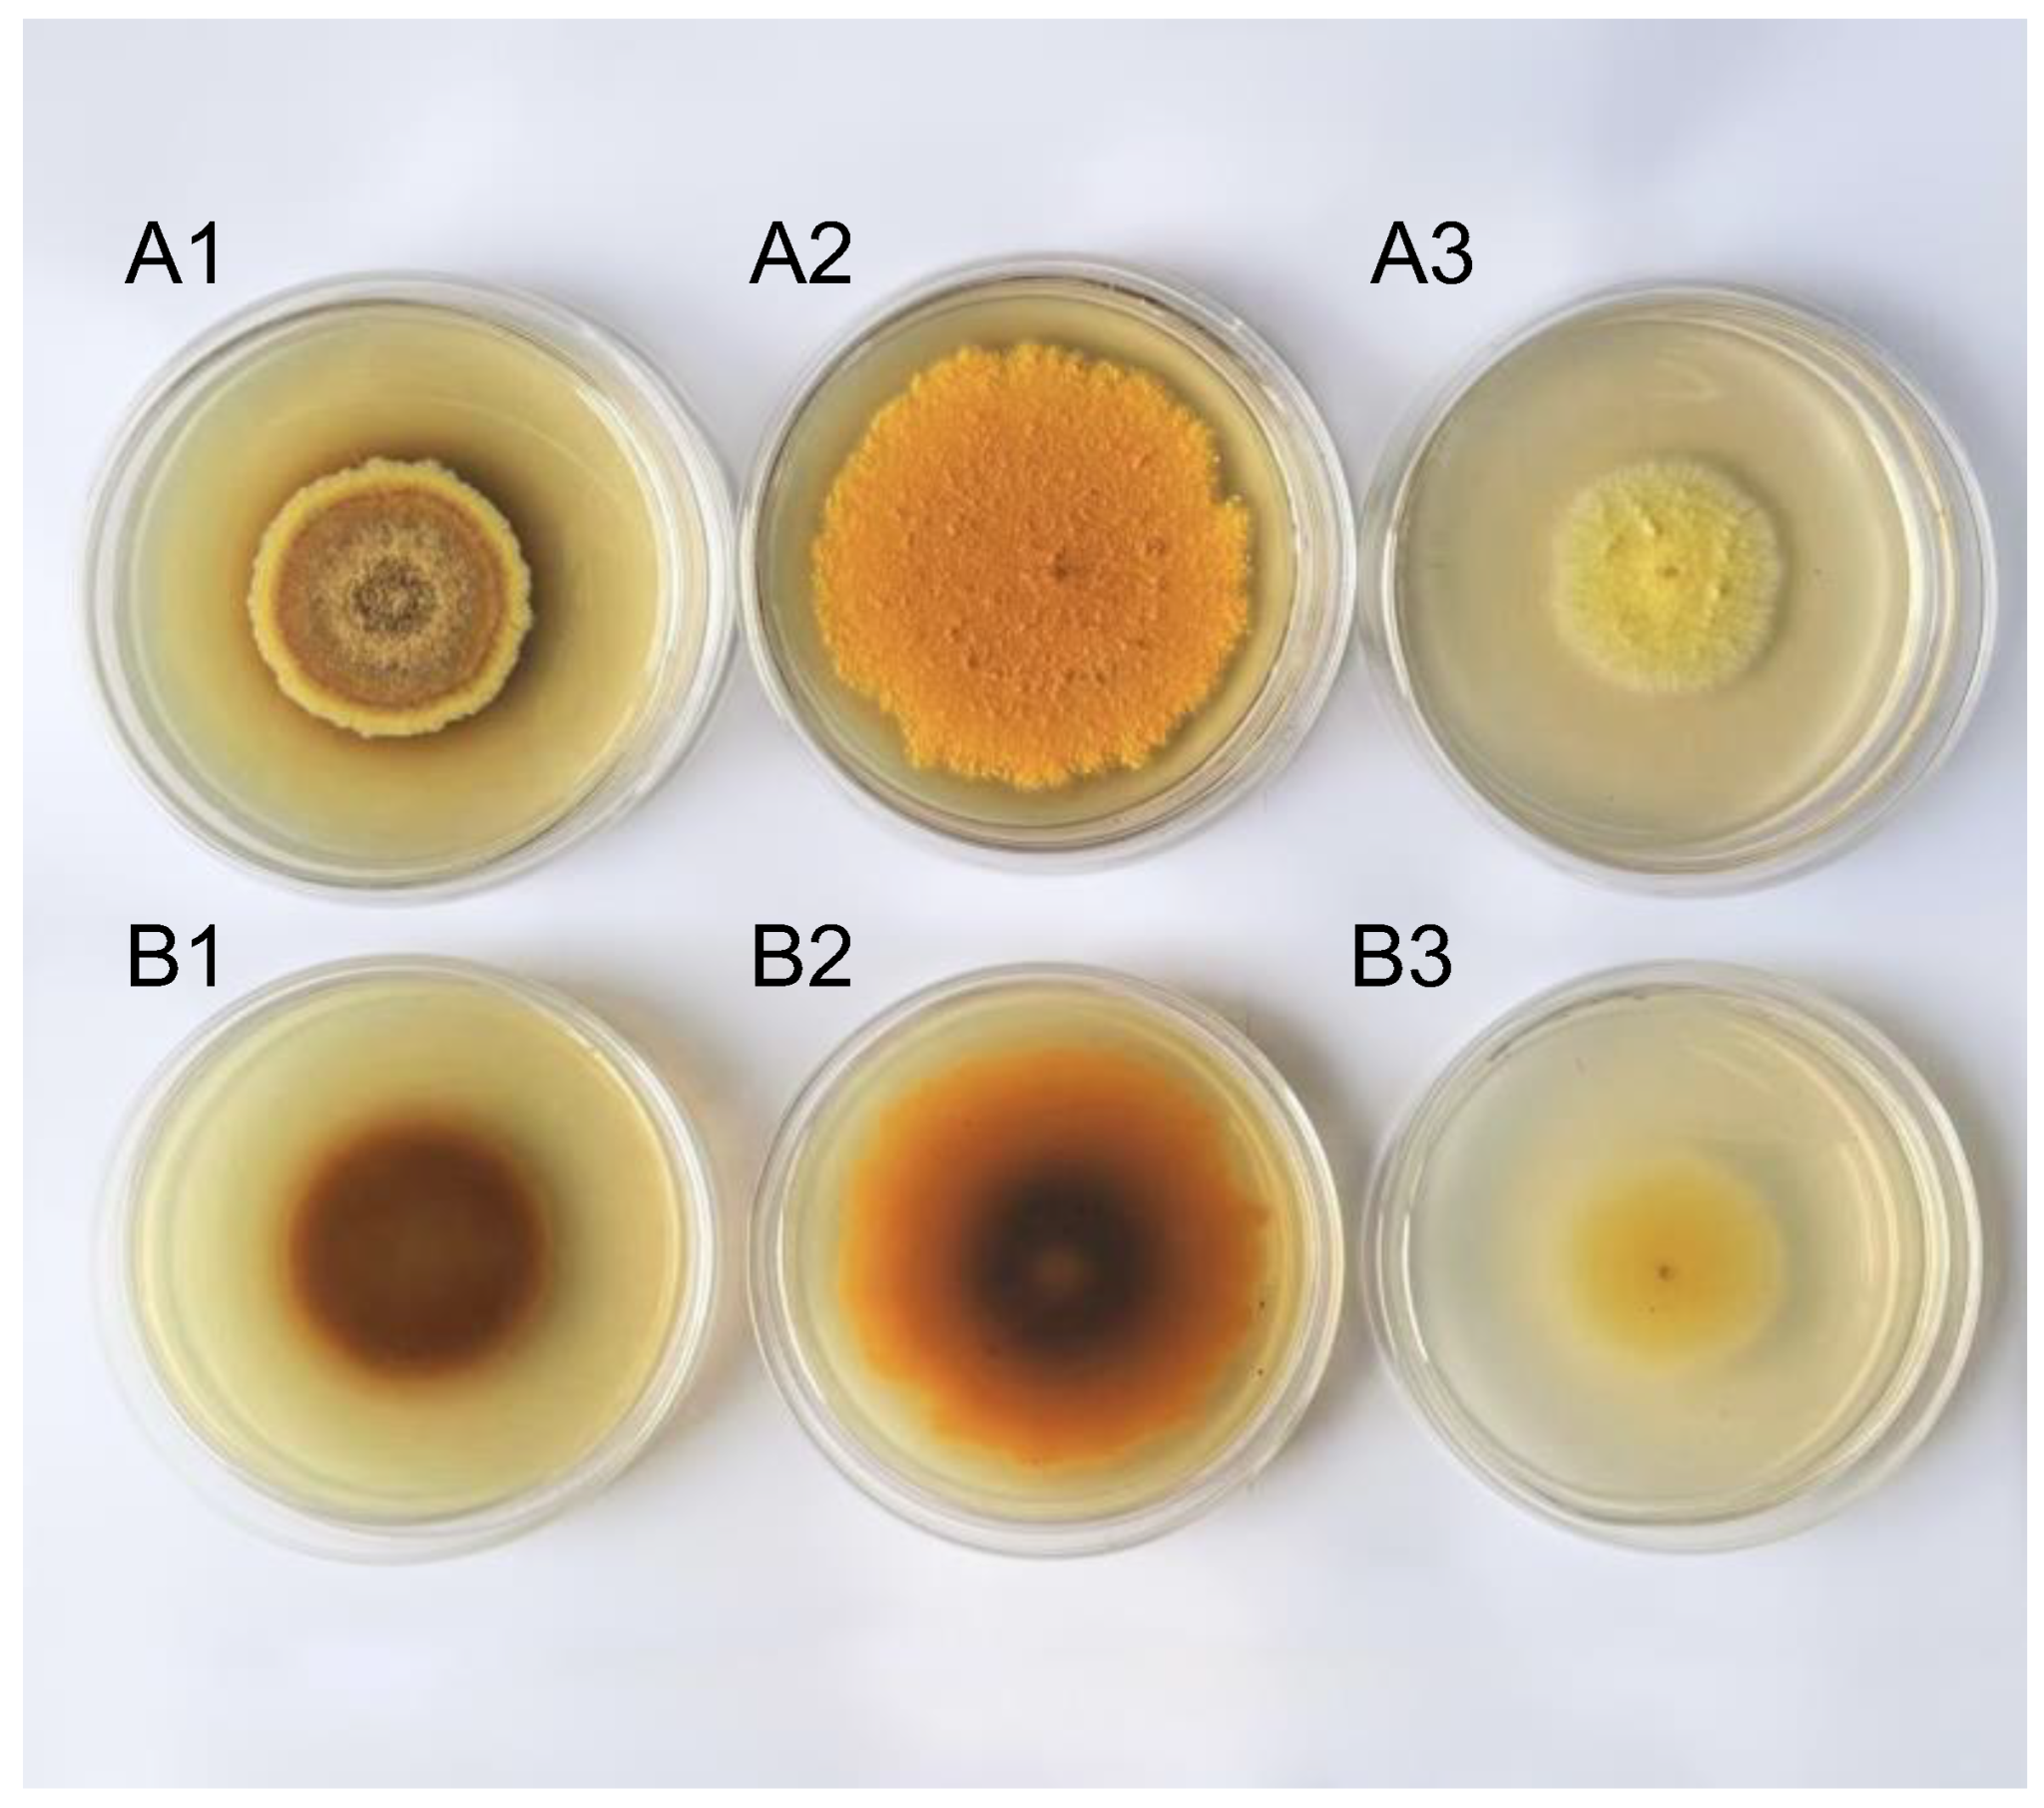

Material Composition Characteristics of Aspergillus cristatus under High Salt Stress through LC–MS Metabolomics
Abstract
1. Introduction
2. Results and Analysis
2.1. Differences Were Observed in Pigment Substances Synthesized by A. cristatus under Different Osmotic Pressures
2.2. Significant Differences Were Noted in the Mycelial Composition of A. cristatus Grown under Different Osmotic Pressures
2.3. Different Substances of A. cristatus Mycelia under Different Osmotic Pressures
2.3.1. Flavonoids and Isoflavonoids
2.3.2. Organic Oxygen Compounds
2.3.3. Amino Acids and Their Derivatives
2.3.4. Nucleosides
2.3.5. Vitamins
2.3.6. Toxins
2.3.7. Hormone Classes
2.3.8. Alkaloids
2.4. Metabolic Pathway Analysis
2.5. Antioxidant Activity and Correlation Analysis of A. cristatus under Different Osmotic Pressures
2.5.1. Significant Differences Were Noted in the Antioxidant Activity of A. cristatus Mycelia under Different Osmotic Pressures
2.5.2. Correlation Analysis
3. Discussion
3.1. From Low to High Osmotic Pressure, Various Substances Changed Significantly in A. cristatus, and the Change Intensity Was Large and Involved Seven Main Change Modes
3.2. Arabitol and Fructose-1,6-diphosphate Are the Main Osmotic Regulators of A. cristatus in Response to a High-Salt Environment
3.3. A. cristatus Reduced the Growth Rate in a High-Salt Environment, Accumulated Survival Competitive Substances, and Initiated Oxidative Stress and Antioxidant Defense System
4. Materials and Methods
4.1. Strains and Reagents
4.1.1. Strains
4.1.2. Medium
4.1.3. Main Reagents
4.2. Main Instruments and Equipment
4.3. Culture Method of A. cristatus on Different Osmotic Pressure Media
4.3.1. Preparation Method of Different Osmotic Pressure Media
4.3.2. Culture of A. cristatus on Different Osmotic Pressure Media and Mycelium Preparation Method
4.4. Determination of Antioxidant Capacity
4.4.1. Assessment of ABTS Free-Radical Scavenging
4.4.2. Assessment of DPPH Free-Radical Scavenging
4.4.3. Assessment of Lipid Peroxidation Inhibition
4.4.4. Assessment of Ferric Ion-Reducing Antioxidant Power
4.5. LC–MS Non-Targeted Metabolomics Detection Method
4.5.1. Sample Preparation
4.5.2. Liquid Chromatography Conditions
4.5.3. Mass Spectrum Conditions
4.5.4. Data Preprocessing
4.5.5. Metabolite Identification
4.6. Statistics and Multivariate Analysis
5. Conclusions
Supplementary Materials
Author Contributions
Funding
Institutional Review Board Statement
Informed Consent Statement
Data Availability Statement
Conflicts of Interest
References
- Gunde-Cimerman, N.; Plemenitaš, A.; Oren, A. Strategies of Adaptation of Microorganisms of the Three Domains of Life to High Salt Concentrations. FEMS Microbiol. Rev. 2018, 42, 353–375. [Google Scholar] [CrossRef] [PubMed]
- Kogej, T.; Stein, M.; Volkmann, M.; Gorbushina, A.A.; Galinski, E.A.; Gunde-Cimerman, N. Osmotic Adaptation of the Halophilic Fungus Hortaea Werneckii: Role of Osmolytes and Melanization. Microbiology 2007, 153, 4261–4273. [Google Scholar] [CrossRef] [PubMed]
- Chen, D.-D.; Fang, B.-Z.; Manzoor, A.; Liu, Y.-H.; Li, L.; Mohamad, O.A.A.; Shu, W.-S.; Li, W.-J. Revealing the Salinity Adaptation Mechanism in Halotolerant Bacterium Egicoccus Halophilus EGI 80432T by Physiological Analysis and Comparative Transcriptomics. Appl. Microbiol. Biotechnol. 2021, 105, 2497–2511. [Google Scholar] [CrossRef]
- Jiménez-Gómez, I.; Valdés-Muñoz, G.; Moreno-Ulloa, A.; Pérez-Llano, Y.; Moreno-Perlín, T.; Silva-Jiménez, H.; Barreto-Curiel, F.; del Sánchez-Carbente, M.R.; Folch-Mallol, J.L.; Gunde-Cimerman, N.; et al. Surviving in the Brine: A Multi-Omics Approach for Understanding the Physiology of the Halophile Fungus Aspergillus Sydowii at Saturated NaCl Concentration. Front. Microbiol. 2022, 13. [Google Scholar] [CrossRef]
- Beever, R.E.; Laracy, E.P. Osmotic Adjustment in the Filamentous Fungus Aspergillus Nidulans. J. Bacteriol. 1986, 168, 1358–1365. [Google Scholar] [CrossRef] [PubMed]
- Jiménez-Gómez, I.; Valdés-Muñoz, G.; Moreno-Perlin, T.; Mouriño-Pérez, R.R.; del Sánchez-Carbente, M.R.; Folch-Mallol, J.L.; Pérez-Llano, Y.; Gunde-Cimerman, N.; del Sánchez, N.C.; Batista-García, R.A. Haloadaptative Responses of Aspergillus Sydowii to Extreme Water Deprivation: Morphology, Compatible Solutes, and Oxidative Stress at NaCl Saturation. J. Fungi 2020, 6, 316. [Google Scholar] [CrossRef] [PubMed]
- Ding, X.; Liu, K.; Lu, Y.; Gong, G. Morphological, Transcriptional, and Metabolic Analyses of Osmotic-Adapted Mechanisms of the Halophilic Aspergillus Montevidensis ZYD4 under Hypersaline Conditions. Appl. Microbiol. Biotechnol. 2019, 103, 3829–3846. [Google Scholar] [CrossRef]
- Kis-Papo, T.; Weig, A.R.; Riley, R.; Peršoh, D.; Salamov, A.; Sun, H.; Lipzen, A.; Wasser, S.P.; Rambold, G.; Grigoriev, I.V.; et al. Genomic Adaptations of the Halophilic Dead Sea Filamentous Fungus Eurotium Rubrum. Nat. Commun. 2014, 5, 3745. [Google Scholar] [CrossRef] [PubMed]
- Tafer, H.; Poyntner, C.; Lopandic, K.; Sterflinger, K.; Piñar, G. Back to the Salt Mines: Genome and Transcriptome Comparisons of the Halophilic Fungus Aspergillus Salisburgensis and Its Halotolerant Relative Aspergillus Sclerotialis. Genes 2019, 10, 381. [Google Scholar] [CrossRef]
- Kogej, T.; Ramos, J.; Plemenitaš, A.; Gunde-Cimerman, N. The Halophilic Fungus Hortaea Werneckii and the Halotolerant Fungus Aureobasidium Pullulans Maintain Low Intracellular Cation Concentrations in Hypersaline Environments. Appl. Environ. Microbiol. 2005, 71, 6600–6605. [Google Scholar] [CrossRef]
- Plemenitaš, A.; Lenassi, M.; Konte, T.; Kejžar, A.; Zajc, J.; Gostinčar, C.; Gunde-Cimerman, N. Adaptation to High Salt Concentrations in Halotolerant/Halophilic Fungi: A Molecular Perspective. Front. Microbiol. 2014, 5. [Google Scholar] [CrossRef] [PubMed]
- Henry, C.; Bledsoe, S.W.; Griffiths, C.A.; Kollman, A.; Paul, M.J.; Sakr, S.; Lagrimini, L.M. Differential Role for Trehalose Metabolism in Salt-Stressed Maize. Plant Physiol. 2015, 169, 1072–1089. [Google Scholar] [CrossRef] [PubMed]
- Gostinčar, C.; Lenassi, M.; Gunde-Cimerman, N.; Plemenitaš, A. Fungal Adaptation to Extremely High Salt Concentrations. In Advances in Applied Microbiology; Academic Press: Cambridge, MA, USA, 2011; pp. 71–96. [Google Scholar]
- Kralj Kunčič, M.; Kogej, T.; Drobne, D.; Gunde-Cimerman, N. Morphological Response of the Halophilic Fungal Genus Wallemia to High Salinity. Appl. Environ. Microbiol. 2010, 76, 329–337. [Google Scholar] [CrossRef] [PubMed]
- Pérez-Llano, Y.; Rodríguez-Pupo, E.C.; Druzhinina, I.S.; Chenthamara, K.; Cai, F.; Gunde-Cimerman, N.; Zalar, P.; Gostinčar, C.; Kostanjšek, R.; Folch-Mallol, J.L.; et al. Stress Reshapes the Physiological Response of Halophile Fungi to Salinity. Cells 2020, 9, 525. [Google Scholar] [CrossRef] [PubMed]
- Rodríguez-Pupo, E.C.; Pérez-Llano, Y.; Tinoco-Valencia, J.R.; Sánchez, N.S.; Padilla-Garfias, F.; Calahorra, M.; del Sánchez, N.C.; Sánchez-Reyes, A.; del Rodríguez-Hernández, M.R.; Peña, A.; et al. Osmolyte Signatures for the Protection of Aspergillus Sydowii Cells under Halophilic Conditions and Osmotic Shock. J. Fungi 2021, 7, 414. [Google Scholar] [CrossRef] [PubMed]
- Ge, Y.; Wang, Y.; Liu, Y.; Tan, Y.; Ren, X.; Zhang, X.; Hyde, K.D.; Liu, Y.; Liu, Z. Comparative Genomic and Transcriptomic Analyses of the Fuzhuan Brick Tea-Fermentation Fungus Aspergillus Cristatus. BMC Genom. 2016, 17, 428. [Google Scholar] [CrossRef]
- Ge, Y.; Yu, F.; Tan, Y.; Zhang, X.; Liu, Z. Comparative Transcriptome Sequence Analysis of Sporulation-Related Genes of Aspergillus Cristatus in Response to Low and High Osmolarity. Curr. Microbiol. 2017, 74, 806–814. [Google Scholar] [CrossRef]
- Liu, K.-H.; Ding, X.-W.; Narsing Rao, M.P.; Zhang, B.; Zhang, Y.-G.; Liu, F.-H.; Liu, B.-B.; Xiao, M.; Li, W.-J. Morphological and Transcriptomic Analysis Reveals the Osmoadaptive Response of Endophytic Fungus Aspergillus Montevidensis ZYD4 to High Salt Stress. Front. Microbiol. 2017, 8. [Google Scholar] [CrossRef]
- Xiao, Y.; Li, M.; Liu, Y.; Xu, S.; Zhong, K.; Wu, Y.; Gao, H. The Effect of Eurotium Cristatum (MF800948) Fermentation on the Quality of Autumn Green Tea. Food Chem. 2021, 358, 129848. [Google Scholar] [CrossRef]
- Efimenko, T.A.; Shanenko, E.F.; Mukhamedzhanova, T.G.; Efremenkova, O.V.; Nikolayev, Y.A.; Bilanenko, E.N.; Gernet, M.V.; Grishin, A.G.; Serykh, I.N.; Shevelev, S.V.; et al. Eurotium Cristatum Postfermentation of Fireweed and Apple Tree Leaf Herbal Teas. Int. J. Food Sci. 2021, 2021, 6691428. [Google Scholar] [CrossRef]
- Xiao, Y.; He, C.; Chen, Y.; Ho, C.-T.; Wu, X.; Huang, Y.; Gao, Y.; Hou, A.; Li, Z.; Wang, Y.; et al. UPLC–QQQ–MS/MS-Based Widely Targeted Metabolomic Analysis Reveals the Effect of Solid-State Fermentation with Eurotium Cristatum on the Dynamic Changes in the Metabolite Profile of Dark Tea. Food Chem. 2022, 378, 131999. [Google Scholar] [CrossRef]
- Xiao, Y.; Zhong, K.; Bai, J.; Wu, Y.; Gao, H. Insight into Effects of Isolated Eurotium Cristatum from Pingwu Fuzhuan Brick Tea on the Fermentation Process and Quality Characteristics of Fuzhuan Brick Tea. J. Sci. Food Agric. 2020, 100, 3598–3607. [Google Scholar] [CrossRef] [PubMed]
- van Iersel, M.L.P.S.; Cnubben, N.H.P.; Smink, N.; Koeman, J.H.; van Bladeren, P.J. Interactions of Prostaglandin A2 with the Glutathione-Mediated Biotransformation System. Biochem. Pharmacol. 1999, 57, 1383–1390. [Google Scholar] [CrossRef] [PubMed]
- Warris, A.; Ballou, E.R. Oxidative Responses and Fungal Infection Biology. Semin. Cell Dev. Biol. 2019, 89, 34–46. [Google Scholar] [CrossRef] [PubMed]
- Miller, G.; Suzuki, N.; Ciftci-Yilmaz, S.; Mittler, R. Reactive Oxygen Species Homeostasis and Signalling during Drought and Salinity Stresses. Plant Cell Environ. 2010, 33, 453–467. [Google Scholar] [CrossRef]
- Kumar, S.; Kalyanasundaram, G.T.; Gummadi, S.N. Differential Response of the Catalase, Superoxide Dismutase and Glycerol-3-Phosphate Dehydrogenase to Different Environmental Stresses in Debaryomyces Nepalensis NCYC 3413. Curr. Microbiol. 2011, 62, 382–387. [Google Scholar] [CrossRef] [PubMed]
- Ren, X.; Bao, Y.; Zhu, Y.; Liu, S.; Peng, Z.; Zhang, Y.; Zhou, G. Isorhamnetin, Hispidulin, and Cirsimaritin Identified in Tamarix Ramosissima Barks from Southern Xinjiang and Their Antioxidant and Antimicrobial Activities. Molecules 2019, 24, 390. [Google Scholar] [CrossRef]
- Liu, K.; Zhao, F.; Yan, J.; Xia, Z.; Jiang, D.; Ma, P. Hispidulin: A Promising Flavonoid with Diverse Anti-Cancer Properties. Life Sci. 2020, 259, 118395. [Google Scholar] [CrossRef]
- Stompor, M. A Review on Sources and Pharmacological Aspects of Sakuranetin. Nutrients 2020, 12, 513. [Google Scholar] [CrossRef]
- Li, J.; Wang, T.; Liu, P.; Yang, F.; Wang, X.; Zheng, W.; Sun, W. Hesperetin Ameliorates Hepatic Oxidative Stress and Inflammation via the PI3K/AKT-Nrf2-ARE Pathway in Oleic Acid-Induced HepG2 Cells and a Rat Model of High-Fat Diet-Induced NAFLD. Food Funct. 2021, 12, 3898–3918. [Google Scholar] [CrossRef]
- Abarikwu, S.O.; Njoku, R.-C.C.; John, I.G.; Amadi, B.A.; Mgbudom-Okah, C.J.; Onuah, C.L. Antioxidant and Anti-Inflammatory Protective Effects of Rutin and Kolaviron against Busulfan-Induced Testicular Injuries in Rats. Syst. Biol. Reprod. Med. 2022, 68, 151–161. [Google Scholar] [CrossRef] [PubMed]
- Shen, T.; Li, H.-Z.; Li, A.-L.; Li, Y.-R.; Wang, X.-N.; Ren, D.-M. Homoeriodictyol Protects Human Endothelial Cells against Oxidative Insults through Activation of Nrf2 and Inhibition of Mitochondrial Dysfunction. Vascul Pharmacol. 2018, 109, 72–82. [Google Scholar] [CrossRef] [PubMed]
- Slyshenkov, V.S.; Dymkowska, D.; Wojtczak, L. Pantothenic Acid and Pantothenol Increase Biosynthesis of Glutathione by Boosting Cell Energetics. FEBS Lett. 2004, 569, 169–172. [Google Scholar] [CrossRef] [PubMed]
- Morell, S.; Follmann, H.; De Tullio, M.; Häberlein, I. Dehydroascorbate and Dehydroascorbate Reductase Are Phantom Indicators of Oxidative Stress in Plants. FEBS Lett. 1997, 414, 567–570. [Google Scholar] [CrossRef] [PubMed]
- Oren, A. Bioenergetic Aspects of Halophilism. Microbiol. Mol. Biol. Rev. 1999, 63, 334–348. [Google Scholar] [CrossRef] [PubMed]
- Peng, J.; Zhang, D.; Ma, Y.; Wang, G.; Guo, Z.; Lu, J. Protective Effect of Fluvastatin on Influenza Virus Infection. Mol. Med. Rep. 2014, 9, 2221–2226. [Google Scholar] [CrossRef]
- Tavakkoli, A.; Johnston, T.P.; Sahebkar, A. Antifungal Effects of Statins. Pharmacol. Ther. 2020, 208, 107483. [Google Scholar] [CrossRef] [PubMed]
- Xiao, X.; Zhou, L.; Ma, X. Effect of Adding Perilla Leaf to Monascus Fermentation on Its Antioxidant Activity. China Brewing. 2011, 30, 50–53. [Google Scholar]
- Wang, B.S.; Li, B.S.; Zeng, Q.X.; Liu, H.X. Antioxidant and Free Radical Scavenging Activities of Pigments Extracted from Molasses Alcohol Wastewater. Food Chem. 2008, 107, 1198–1204. [Google Scholar] [CrossRef]
- Wu, S.; Zhang, J.; Chen, Y.; Zhong, L. Screening and Identification of Lactic Acid Bacteria Strains with Antioxidant activities in Fermented Food. J. Zhejiang Univ. Technol. 2019, 47, 685–691. [Google Scholar]

Disclaimer/Publisher’s Note: The statements, opinions and data contained in all publications are solely those of the individual author(s) and contributor(s) and not of MDPI and/or the editor(s). MDPI and/or the editor(s) disclaim responsibility for any injury to people or property resulting from any ideas, methods, instructions or products referred to in the content. |
© 2024 by the authors. Licensee MDPI, Basel, Switzerland. This article is an open access article distributed under the terms and conditions of the Creative Commons Attribution (CC BY) license (https://creativecommons.org/licenses/by/4.0/).
Share and Cite
Xie, L.; Zhou, L.; Zhang, R.; Zhou, H.; Yang, Y. Material Composition Characteristics of Aspergillus cristatus under High Salt Stress through LC–MS Metabolomics. Molecules 2024, 29, 2513. https://doi.org/10.3390/molecules29112513
Xie L, Zhou L, Zhang R, Zhou H, Yang Y. Material Composition Characteristics of Aspergillus cristatus under High Salt Stress through LC–MS Metabolomics. Molecules. 2024; 29(11):2513. https://doi.org/10.3390/molecules29112513
Chicago/Turabian StyleXie, Luyi, Lihong Zhou, Rongrong Zhang, Hang Zhou, and Yi Yang. 2024. "Material Composition Characteristics of Aspergillus cristatus under High Salt Stress through LC–MS Metabolomics" Molecules 29, no. 11: 2513. https://doi.org/10.3390/molecules29112513
APA StyleXie, L., Zhou, L., Zhang, R., Zhou, H., & Yang, Y. (2024). Material Composition Characteristics of Aspergillus cristatus under High Salt Stress through LC–MS Metabolomics. Molecules, 29(11), 2513. https://doi.org/10.3390/molecules29112513
